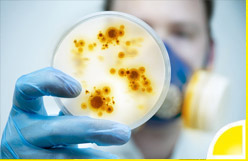
Hygieneinspektion Hygieneinspektion von KLH Tec

Bei der Planung sanitärer Einrichtungen für Industrie, Gewerbe und die öffentliche Hand ist es nicht mit der Wahl des richtigen Waschbeckens und der dazu passenden Armatur getan. Von der individuellen Beratung über die Konzeption bis zur Ausschreibung plant KLH-TEC effiziente Lösungen im Bereich Sanitärtechnik.
Die Entscheidung für die passende Heizungsanlage muss wohl durchdacht sein - sei es in einem Supermarkt, einer Produktionshalle oder einem öffentlichen Gebäude. Auf der Basis aller relevanten Kriterien erarbeiten wir ein auf die Bedürfnisse Ihres Unternehmens zugeschnittenes Konzept für Ihre Heizungsanlage.
Im Bereich der Hygienetechnik begleiten wir Sie umfassend: von der Beratung bis zur termingerechten Ausführung. Unser Büro übernimmt für Sie die vorgeschriebene Hygieneinspektion nach VDI 6022 - damit Sie als Arbeitgeber oder Betreiber eines öffentlichen Gebäudes gesetzlich auf Nummer sicher gehen.
Gesunde Luft: Lassen Sie Ihre Mitarbeiter durchatmen!
Zertifizierte Gutachter führen Hygieneinspektionen nach VDI 6022 durch.
Reaktionsstark
Unser Team aus erfahrenen Mitarbeitern unterschiedlicher Fachrichtungen unterbreitet Ihnen kurzfristig detaillierte Planungs- und Berechnungsvorschläge.
Geradlinig
Konsequente Planung und Ausführung helfen Ihnen, Ihre neue Gebäudetechnik termingerecht in Betrieb zu nehmen und kostengünstig zu unterhalten.
Kundenorientiert
Abgestimmt auf Ihre persönlichen Anforderungen schaffen wir Lösungen, die zu nachhaltigem Mehrwert und einer langfristigen Partnerschaft führen.
Besuchen Sie uns
Im Gewerbegebiet 12
91183 Abenberg
Terminvereinbarung unter
Telefon 09178 / 9969248
Mail: info@klh-tec.de